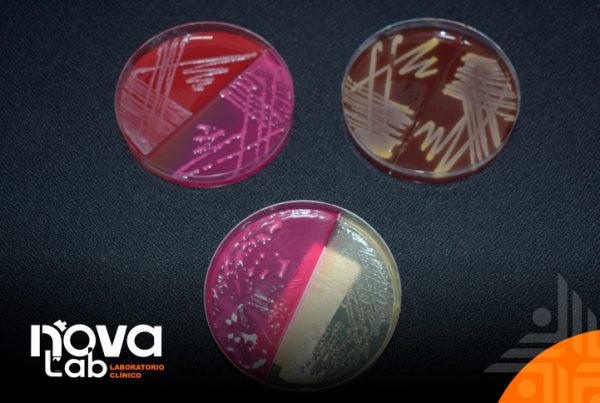

abril 26, 2024
Cálculos Renales
En Novaclínica, nos impulsa trabajar y mejorar para ofrecer la mejor atención sanitaria a nuestros pacientes. Por esta razón, hemos invertido en equipos de vanguardia tecnológica para estudios de tomografía…